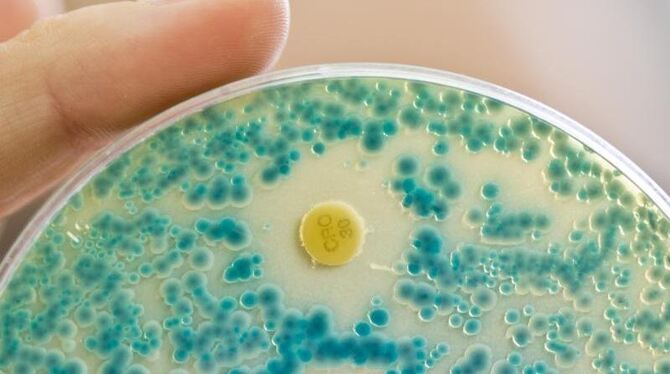

Verdacht: Tödliche Keime durch indische Pharma-Abwässer
Indische Antibiotika-Fabriken stehen im Verdacht, durch mangelnde Abwasserreinigung zur Entstehung multi-resistenter Bakterien beitragen. Foto: Daniel Karmann
Lorem ipsum dolor sit amet, consetetur sadipscing elitr, sed diam nonumy eirmod tempor invidunt ut labore et dolore magna aliquyam erat, sed diam voluptua. At vero eos et accusam et justo duo dolores et ea rebum.
